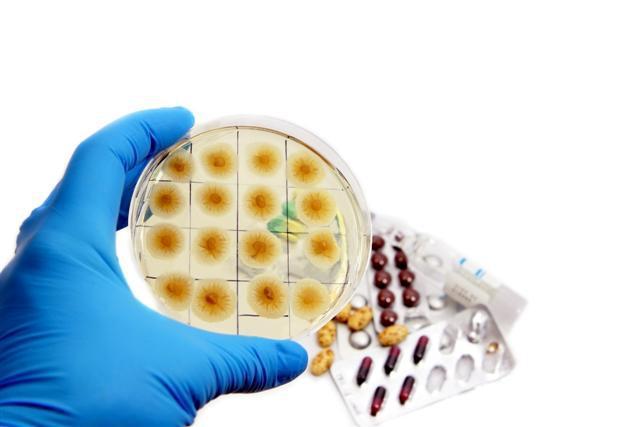
LA PENICILINA

-
Por su gran utilidad en la mecánica, actualmente uno de los inventos más importantes, también en el transporte terrestre y como componente fundamental de diversas máquinas. El conocimiento de su origen se pierde en el tiempo (entre 3350 a. C. al 3100 a. C), pues nadie sabe quién la invento y sus múltiples usos han sido esenciales en el desarrollo del progreso humano.
Máquina simple que no deja de ser imprescindible para el desarrollo del ser humano.
https://www.youtube.com/watch?v=GmCwYLZv7KM -
Los inventos relacionados en la presente linea de tiempo, son producto del descubrimiento y comprensión de los eres humanos al respecto de fenómenos naturales, necesidades y/o combinación de otras invenciones previas; sin embargo, representan un gran avance intelectual y la mejora de la calidad de vida de las personas.
-
Aunque los registros asociados a su invención datan de la antigua China, no fue sino hasta el año 1450 con el ruso Johannes Gutenberg que se creo la imprenta moderna, que sin duda revolucionó la historia de la humanidad. en todas las sociedades del mundo, porque ella implica una innovación no solamente en el campo de la escritura, sino en el de la ciencia, el arte, la cultura, la política, la religión y muchas otras áreas.
-
Hoy día, no podemos concebir nuestras vidas sin la electricidad. Se define como el flujo de partículas cargadas llamadas electrones a través de un medio conductor. Aunque no es fácil determinar quien la descubrió si hay bastantes precursores que trabajaron al rededor de su comprensión:En 1660, Otto von Guericke inventó el generador electro estático que genera electricidad estática.En 1729, Stephen Gray, define la conducción de la electricidad; Benjamín Franklin y Michael Faraday entre otros.
-
La invención de tan significativo arefacto fue obra de dos genios: el inglés Joseph W.Swan (1828 – 1914) y el norteamericano Thomas Alva Edison (1847 – 1931). La primera bombilla eléctrica vio la luz y se hizo el 21 de octubre de 1879 tras muchos años de experimentos y fracasos. Finalmente, la transformación de la electricidad en luz le ha dado la vuelta al mundo, y aunque el sistema patentado por Edison poco a poco se ha cambiado por otros, no ha dejado de se ser imprescindible para el hombre.
-
Aunque la idea de un vehículo personal capaz de transportar a la gente ya existía desde hacía un largo tiempo, Karl Benz, de los famosos Mercedes Benz, es reconocido como el creador del primer automóvil a gasolina. Su coche era un vehículo de tres ruedas con un motor de cuatro tiempos. Este coche primordial fue creado entre 1885 y 1886 y fue patentado en Alemania. Pronto la Revolución Industrial y Henry Ford produjeron automóviles en masa, y comenzó la locura automovilística en el mundo.
-
Uno de los inventos más grandes del siglo XX. Tal maravilla la agradecemos a los hermanos Wright (Wilbur y Orville), quienes comenzaron a trabajar en la idea de construir aviones en 1899. Finalmente tuvieron éxito en volar el primer avión el 17 de diciembre de 1903.
https://www.youtube.com/watch?v=mBGVnwGRa34, en aquél día histórico el avión de los hermanos Wrigth obtuvo un vuelo que duró 59 segundos, alcanzando una altura de 120 pies, el planeador cubrió una distancia de 852 pies. -
Aunque quizá no se trate de un invento que salve muchas vidas, si resulta significativo para la vida de millones de seres humanos en el mundo. Fue inventada en el año 1924 por el ingeniero, físico e inventor John Logie Baird, quién nació en Escocia, el 13 de agosto de 1888. en aquel entonces sólo se transmitían imágenes sencillas de figuras, haciendo uso de cableado telefónico u ondas de radio.
Es claro que su evolución ha sido acelerada hasta la tecnología SMART que disfrutamos hoy en día. -
Fue uno de los primeros antibióticos que se inventaron y también uno de los que más se utilizaron en todo el mundo. Durante años, gracias a los descubrimientos de su creador Alexander Fleming, además, han salvado la vida de millones de personas, razón por la cual esta invención constituye una de las más importantes de la historia. El descubrimiento de la penicilina ocurrió por "casualidad" en la mañana del 28 de septiembre de 1928 tras la incidencia de hongos Penicillium en un experimento.
-
Mucho se especula al respecto de un inventor concreto, sin embargo, la idea de una red de comunicación nacer en los estados unidos con fines gubernamentales en la década de 1960, con el fin de establecer una red de comunicaciones denominada ARPAnet. El uso de internet creció rápidamente en el hemisferio occidental desde la mitad de la década de 1990, y desde el final de la década en el resto del mundo. En 2015 a la tercera parte de la población mundial tiene acceso a Internet.
-
Resulta una herramienta imprescindible para cualquiera de nosotros, pero ¿A quién debemos tan revolucionario invento?. Martin Cooper, graduado en Ingeniería Eléctrica en el Instituto de Tecnología de Illinois. El 3 de abril 1973 presentó el primer prototipo del teléfono celular: Motorola Dyna-Tac. Este día se hizo la primera llamada de teléfono móvil, que fue realizada por el Sr. Cooper.
y ¿Cuánto costaba en el Dyna-Tac? ¡$3.500! Sí, así es, la módica suma de de tres mil quinientos dólares!
Plan projects on a visual timeline
Map milestones, phases, deadlines, and key events in one place so the sequence is easier to see and share. Timetoast is a timeline maker for work, school, research, and stories.